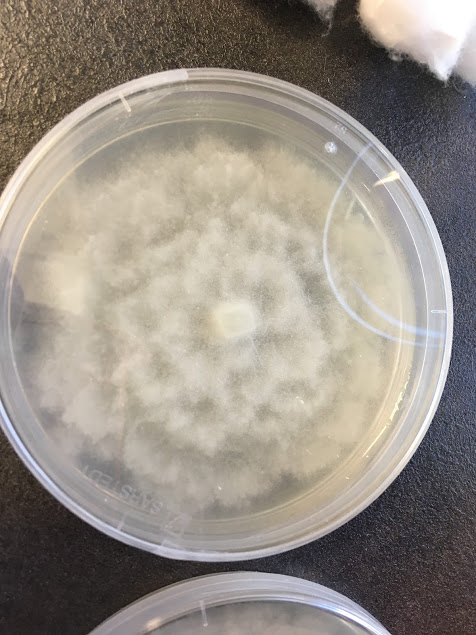

Ensayos de Campo y Laboratorio
- Escrito por:Neval
- 7 abril, 2018
- Los comentarios están cerrados
NEVAL ofrece un amplio catálogo de servicios entre los que se encuentran los ensayos de campo y laboratorio.
Generalmente, cuando el cliente desea testar una formulación, le ofrecemos la fórmula que más información le pueda aportar, en el menor tiempo posible y con una inversión mínima.
Los screenings que se realizan en NEVAL incluyen:
- Estudios con Nematodos in vitro, en maceta con y sin hospedador.
- Estudios con artrópodos, hongos y bacterias en cámara, invernadero o laboratorio.
Tras la verificación de la acción de los productos se deciden las dosis que se van a emplear para registro de productos fitosanitarios o fertilizantes.
En NEVAL disponemos de criaderos de plagas agrícolas todo el año:
- Ácaros: Tetranychus urticae, Eutetranychus orientalis, Aculops lycopersici.
- Trips: Frankiniella occidentalis.
- Cotonet o Cochinilla: Planococcus citri
- Mosca blanca: Bemisia tabaci.
- Pulgón: Aphis fabae, Rophalosiphum padi, Aphis nerii.

En cuanto a hongos y bacterias para inocular trabajamos con cepas certificadas.
Para laboratorio estamos validando desde finales 2017, un protocolo para trabajar en laboratorio contra los posibles vectores de Xylella fastidiosa.
Si está interesado en el Proyecto #AlianzaControlXylella envíe un correo a administración comunicando número de tesis a testar.
Nuestros ingenieros están diseñando una maquinaria para microaplicaciones, de manera que el vector inoculado en las plantas soporte las presiones y se mantenga en el hospedador seleccionado.
Las empresas Agro implicadas en el control de la Xylella fastidiosa, siguen de cerca la evolución de los estudios.
Tras los ensayos de laboratorio con los productos que resulten positivos para una acción contra P. Spumarius y otros, se procederá a realizar los estudios en campo.
Los ensayos de campo y laboratorio se realizan a la carta, dependiendo de las necesidades del cliente, de la plaga, del hospedador.
Para los ensayos de fertilizantes podemos recurrir para hortícolas a nuestro centro experimental, donde tenemos opciones infinitas con los riegos diseñados para optimizar los estudios.
- De 1 a 3 hortícolas por parcela experimental y con RCB (bloques randomizados) totalmente controlados.
- Trabajar en zonas con DOP, IGP, ETG para poder trabajar directamente en zonas donde el producto tiene mayor salida.
- Trabajar en las zonas más cercanas donde se encuentre la plaga y el cultivo elegido para disminuir costes.
Garantizamos el éxito de los estudios realizados, para ello nuestro personal le informará de las condiciones, los momentos adecuados y de ser necesario trabajar con inóculos artificiales.
Disponemos de una red de colaboradores de confianza por todo el territorio español.

Nuestros estudios llevan asociada una carpeta de imágenes que podrá utilizar para demostraciones.
Actualización a tiempo real de los datos de sus estudios.
Entrega de informes en plazo de 7 días.
